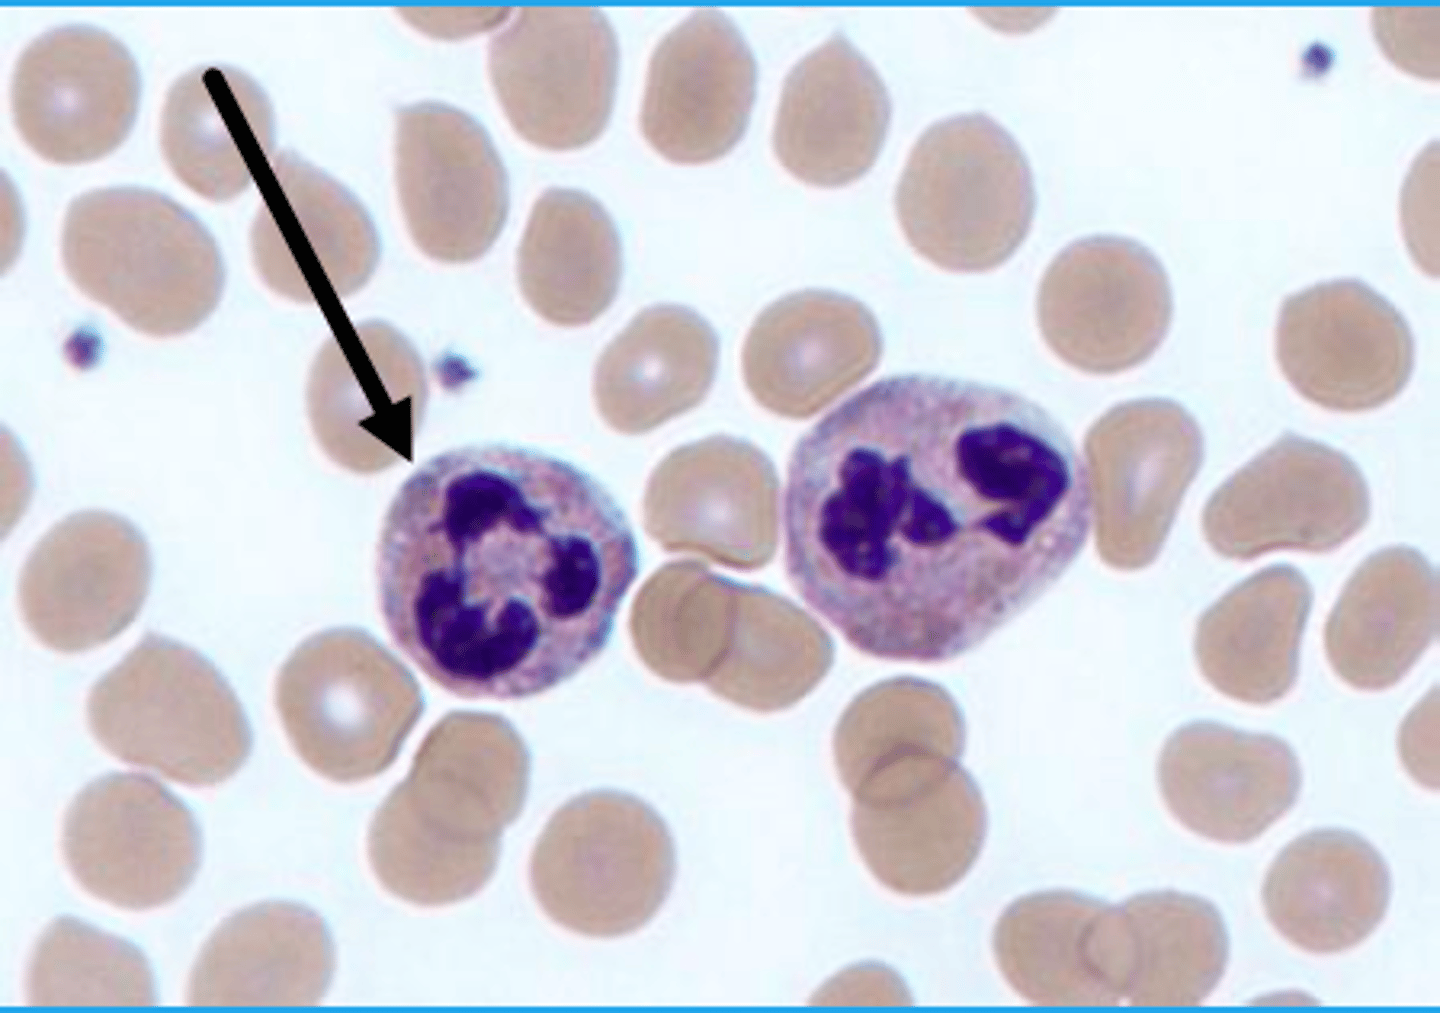
<p>De udgør størstedelen af granulocytterne.</p><p>De indeholder polymorfe kerner</p><p>De modnes i knoglemarven, kommer ud i blodet og vandre til vævet hvor de kun overlever et par dage.</p><p>De er første forsvar mod mikroorganismer, og deres hovedfunktion er fagocytose.</p>
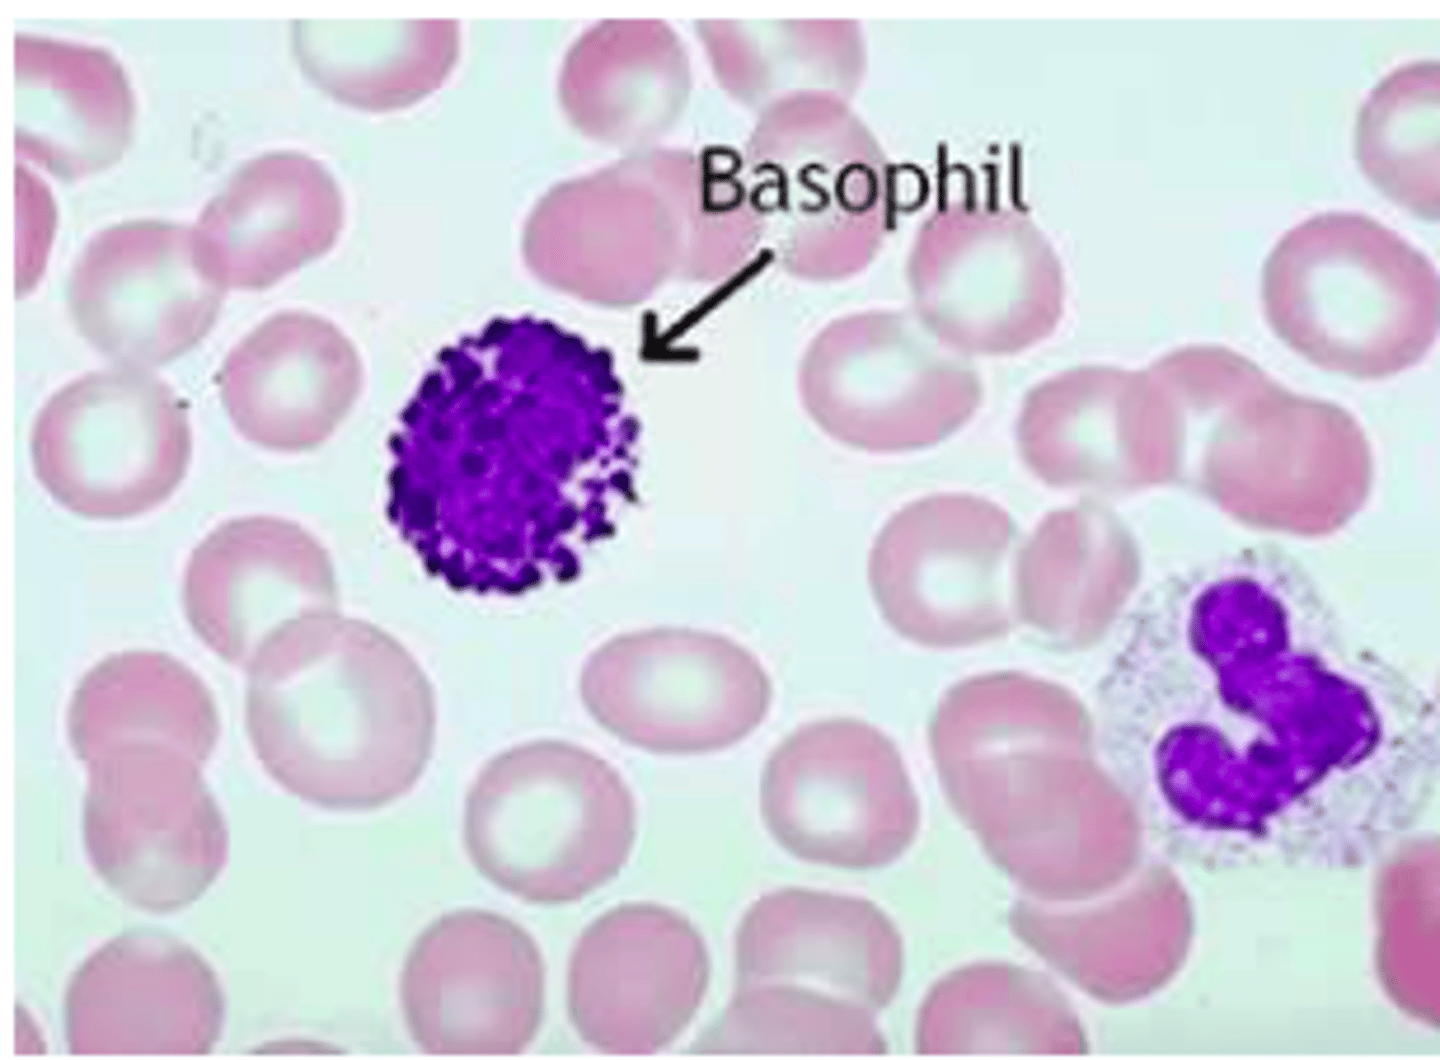
<p>Udgør omkring 1%</p><p>Deres funktion er at inducere inflammation, samt aktivere eller inhibere de andre leukocytter.</p><p>Deres primære funktion er degranulering og dermed hører de ikke under fagocytterne.</p><p>De indeholder en lang række sekretorisk granula og spiller en stor rille i antiparasitisk immunitet og allergiske reaktioner.</p><p>De binder til overfladen af organismer der er for store til at blive fagocyteret og frigiver indholdet i deres granula.</p>

1/457
Looks like no tags are added yet.
Name | Mastery | Learn | Test | Matching | Spaced |
|---|
No study sessions yet.
Hvilken rolle spiller huden i beskyttelse mod mikroorganismer?
Frigiver mælkesyre der er skadelig for mikroorganismer
Hvilken rolle spiller slimhinderne i beskyttelse mod mikroorganismer?
De danner mucus der gør det svært for mikroorganismerne og komme ind i kroppen
Hvilken rolle spiller fimrehår i beskyttelse af kroppen mod mikroorganismer?
De kan slå bakterier og mikroorganismer op fra lungerne og ud til munden så de ikke invaderer lungerne og det respiratoriske system.
Hvilken rolle spiller spyt og og sekret i beskyttelsen af kroppen fra mikroorganismer?
De indeholder enzymer der forhindrer mikroorganismer i at etablere sig.
Hvilke tre typer af celler deler pluripotente stamceller sig til?
1. Nye pluripotente stamceller
2. Stamceller til lymfoide celletyper
3. Stamceller til myeloide celletyper
Hvilke celler hører under de lymfoide celletyper?
B lymfocytter
T lymfocytter
NK celler
Hvilke celler hører under de myeloide celletyper?
Granulocytter
Monocytter
Makrofager
Myeloide dendritiske celler
Erytrocytter
Trombocytter
Beskriv det innate immunsystem
Reaktionstiden er hurtig
Genkender PAMP og DAMP gennem mønstergenkendende receptorer såsom
- PPR
-Kulhydratbindende receptor
-Toll
-NOD
Konstant fra gang til gang
Celler der indgår i det innate immunsystem:
- Neutrofile granulocytter
-Makrofager
-B-1 celler
-Dendritiske celler
Beskriv det adpative immunsystem
Tager dage til uger for responset at gå i gang
Genkender antigener gennem BCR eller TCR
Forbedres fra gang til gang
Celler der indgår i det adaptive immunsystem:
- T celler
-Cytotoktiske celler
-B-2 Celler
Beskriv virkningsmekanismen af det innate immunsystem
Det anvender humorale komponenter der aktivere kroppens fagocytter.
Cellerne genkender bestemte mønstre på bakterierne og mikroorganismerne gennem deres mønstergenkendende receptorer.
Der ses hovedsageligt fagocytose som virkningsmekanisme.

Beskriv virkningsmekanismen af det adaptive immunsystem
De anvender antistoffer som humoralt komponent.
Man finder B lymfocytter der kan udvikle sig til plasmaceller. Th celler der kan danne cytokiner og cytotoksiske t celler der kan dræbe virusinficerede celler.
Cellerne reagerer på antigener, og dermed kræver det tidligere eksponering for et bedre immunrespons.
I begyndelsen findes der kun få B og T celler der genkender agensaen. De skal dermed ekspandere og affinitesmodnes. Herfra bliver immunsystemet dermed bedre og bedre til og genkende mikroorganismerne da de har dannet flere antistoffer imod mikroorganismen.
Jo flere memocy celler kroppen har, jo mindre syg vil man blive af agensaen- man er dermed blevet immun.

Beskriv hvad der sker ved affinitetsmodning
Det er når at antistofferne bliver bedre til og binde til deres antigen.
Beskriv hvad der sker ved klonekspanssion
Specifikke T og B celler genkender en agensa gennem deres BCR og begynder og klone en masse celler
Hvad reagerer receptorerne på i det innate immunsystem?
Molekylære mønstre
Hvad reagerer receptorerne på i det adaptive immunsystem?
Antigener
Beskriv den kulhydratbindende receptorer
Makrofagerne har en mannoreceptor der har et kulhydratbindende område der binder til sukker på en Ca2+ afhængig måde.
De er gode til at binde svampe, parasitter og virus.
Receptoren findes på monocytter, makrofager og dendritiske celler.
Beskriv affaldsreceptoren
Den binder til skadede elementer eller gamle elementer og hjælper med og fjerne dem fra organismen.
De vigtigste affaldsreceptorer er SRA, MARCO og CD36
Beskriv hvordan NK cellen aktiveres og udøver sit angreb
NK cellen bærer flere forskellige receptorer.
Disse receptorer kan binde til MHC II, der ses på stressede celler, hvor NK cellen så vil slå cellen ihjel.
NK cellen har også en KIR receptorer der udtrykker MHC som ses på almindelige celler. Dermed nedreguleres NK cellens virkning.
NK cellen dræber også celler der er dækket med IgG antistoffer, da dette er et tegn på at cellen er virusinficeret.
NK cellens overordnede funktion er at dræbe celler der er virusinficerede eller har ændret sig til cancerceller.
Beskriv de intracellulære mønstergenkendende molekyler
Der findes intracellulære recepotrer der igangsætter drabet på inficernede agenser.
Disse receptorer kaldes for
TLR3, TLR7, TLR8, TLR9
NOD1
NOD2
Hvad gør TLR3, TLR7, TLR8, TLR9
De genkender RNA fra virus.
Receptoreren findes på alle kerneholdige celler.
Hvad gør NOD1
De genkender intracellulære gram negative og positive bakterier og intracellulær virus.
Receptoren findes på alle kerneholdige celler.
Hvad gør NOD2
De genkender intracellulære gam postive og negative bakterier samt intracellulær virus.
De findes på monocytter, dendritiske celler, makrofager og panth celler i tarmen
Beskriv toll lignende receptorer, TLR
De spiller en stor rolle i det innate immunsystem.
Genkender mønstre der er typiske for PAMPS. Efter genkendelse inducerer de et immunrespons.
Indeholder 20-27 leucin ringe der folder sig som en hestesko.
Når receptoren aktiveres, dannes der cytokiner som fremmer immunresponset.
Findes på:
- Makrofager
-Granulocytter
-Dendritiske celler
-NK celler
-B celler
-T celler

Beskriv hvad en b celle epitop er
Genkender antistoffer der sidder på overfladen af mikroorganismer.
Binder direkte til antistoffet.
Sidder på overfladen af antigen molekyler.

Beskriv hvad en T celle epitop er
Genkender fragmenter af antigen proteiner der bliver repræsenteret på MHC.
Det er antigen præsenterende celler der præsenterer antigener for T celler.
(CD8+)
(CD4+)
Antigenerne skal nedbrydes inde i cellen og derefter præsenteres som små dele på MHC molekyler.

Hvordan 'vaccinerede' man første gang en patient
En læge gav kokopper til en dreng.
Efter nogle år kom fænomenet til DK og man fandt ud af at man kan kunne sprøjte døde hønse kolera bakterier ind i patienter, da patienten så ikke blev syg, men stadig blev immun.
Hvad er kollektiner?
Det er et mønstergenkendende molekyle der er opbygget af et kulhydratbindende domæne med en lang stilk af kollagen.
Det er med til bekæmpelsen af en lang række bakterier og vira i det respiratoriske system.
Hvad er ficcoliner?
Det er et mønstergenkendende molekyle der er opbygget af et kulhydratbindende domæne med en lang stilk af fibrinogen.
Det er med til bekæmpelsen af en lang række bakterier og vira i det respiratoriske system.
Hvad er lipopolysakkarid bindende protein, LBP?
Det er et akutfase protein der findes i kroppen, som stiger drastisk under et inflammatorisk respons.
Det bliver hovedsageligt dannet i leveren.
Hvad er naturlige antistoffer?
Det er antostoffer der bliver dannet i organismen, uden tidligere og have været i kontakt med antigen.
Dannes hovedsageligt af B1 celler og hører i høj grad under IgM
Er tilstede fra fødslen og udvikles meget hurtigt
De genkender makromolekyler og mønstre på døde celler og bakterier.
De kan også være med til og rydde døde celler og affald op i kroppen.
Beskriv antigen inducerede antistoffer
De dannes i kroppen efter at have været eksponeret for et antigen.
Dannes af B2 celler
Dannelsen begynder efter infektion eller vaccination
De er meget specifikke over for det antigen der har aktiveret immunsystemet.
De kan undergå klasseskift og blive stærkere med tiden.
Beskriv hvad der når antistoffer bliver affinitesmodnede?
Så bliver de bedre til og binde med deres antigen.
Hvilen celletype danner de naturlige antistoffer?
B1 celler
Hvilke celler danner de antigen inducerede antistoffer?
B2 celler
Hvilke celler hører til det innate immunsystem?
- Neutrofile granulocytter
-Makrofager
-B-1 celler
-Dendritiske celler
Hvilke celler hører til det adaptive immunsystem?
- T celler
-Cytotoktiske celler
-B-2 Celler
Hvilken betydning har komplementsystemet i det innate immunsystem?
Det er en af dets humorale komponenter
Gennem hvilke veje virker komplementsystemet?
Den klassiske aktiveringsvej
Den lektin medierede aktiveringsvej
Den alternative aktiveringsvej
Hvordan er komplementsystemet opbygget?
Det består af 20 plasmaproteiner med 10 membranbundne receptorer og regulatormolekyler, samt en masse opløselige komponenter.
Angiv opbygning af C1
Det er en blomsterlignende struktur med 6 arme, kollagenstilke og globulære hoveder.
Den binder til antistoffer af IgG eller IgM på overfladen af patogener.
Består af tre underenheder
- C1q
-C1s
-C1r
hvor minimum to af hovederne binder til IgM eller IgG.
Binder minimum to af disse, aktiveres C1r.

Angiv opbygningen af MBL
Det er membran bundet lektin, der ses ved den lektin medierede aktiveringsvej.
Her binder lektin til mannan, som er antigener der er opbygget af sukker molekyler.

Angiv opbygningen af MAC
Består af C5b, C6, C7, C8, C9
Beskriv funktionen af C1q
Binder til IgM og IgG
Beskriv funktionen af C1r
Aktiverer C1s
Beskriv funktionen af C1s
Spalter C4 og C2
Beskriv funktionen af MBL
Binder til sukker strukturer
Beskriv funktionen af MASP-1
Aktiverer MASP-2
Beskriv funktionen af MASP-2
Spalter C4 og C2 ligesom C1s
Beskriv funktionen af MAC
Danner en porre i membranen
Hvordan helt overordnet, aktiveres komplementsystemet i kroppen?
Leveren og andre celler i kroppen danner hele tiden komplement proteiner, og skubber dem ind i det cirkulatoriske system.
Når der kommer inflammation i kroppen, så skubbes det ud til det inficerede vævsområde.
Hermed aktiveres komplementsystemet til at gå i gang.
Beskriv den klassiske aktiveringsvej
1. Antigen induceret
2. C1 binder til bakterier der har antigener på overfladen
3. C1 binder til Fc delen af antistoffet
4. C1⮕ C4⮕ C2 ⮕C3b⮕C5b⮕C6⮕C7⮕C8⮕C9
5. Mastceller aktiverer proteaser der aktiverer C3a og C5a der vil øge det inflammatoriske respons.
6. C5b- C9 knækker af og danner MAC, der kan binde til bakteriernes cellemembran og inducere lysering.

Beskriv den alternative aktiveringsvej
1. C3b binder direkte til antigener på bakterien.
2. C3b⮕C5b⮕C6⮕C7⮕C8⮕C9 binder til hinanden
3. C5b-C9 knækker af og danner MAC
4. Dette inducerer lysering af bakterien og den dør
5. C3b er eksponeret og fungerer som opsonin- den gør det nemmere for fagocytter at kunne fagocytere bakterien

Beskriv den lektin medierede aktiveringsvej
Vejen igangsættes gennem MBL eller ficoliner.
1. Antigener der sidder på overfladen er sukkermolekyler der kaldes for mannose
2. Lektin er et protein der kan binde til mannosen
3. C4⮕Lektin ⮕C2⮕C3b⮕C5b⮕C6⮕C7⮕C8⮕C9
4. C5b-C9 knækker af og danner MAC
5. MAC inducerer lysering og gør at bakterien dør
6. C3b sidder igen frit og fungerer som opsonin
Hvad sker der med C3a og C5a?
De frigives hvor de er med til at øge det inflammatoriske respons
Hvad hedder den klassiske C3 konvertase?
C4bC2a
Hvad hedder den klassiske C5 konvertase?
C4bC2aC3b
Hvad hedder den alternative C3 konvertase?
C3bBb
Hvad hedder den alternative C5 konvertase?
C3bBbC3b
Beskriv den lytiske proces som komplementsystemet inducere
Komplementsystemet indcuerer lysering, når MAC dannes og danner en porer i membranen af bakterierne.
Hermed tillades der at der kommer ioner ind i bakterien, hvilket grundet osmotisk tryk, gør at bakterien svulmer op og sprænger.
Hvad er anafylatoksiner?
Det er små proteinstumper der dannes, når komplementsystemet går i gang.
Der er tale om C3a, C5a som de vigtigste og mest dominante.
De fremkalder gennem flere forskellige mekanismer inflammation.
Hvordan virker C3a, og C5a som anafylatoksiner?
1. Øger karpermabilitet
2. Medierer sammentrækning af glat muskulatur
3. Virker kemotaktisk på neutrofile granulocytter og makrofager
4. Igangsætter drabsmekanismer i neutrofile, eosinofile granulocytter og makrofager
5. Stimulerer frigivelse af inflammatoriske og kemotaktiske faktorer fra basofile granulocytter og mastceller
Hvilke anafylatoksiner findes der ud over C3a og C5a?
C4a, C3b, C3d, C5bC69, C1q og MBL
Beskriv hvordan C3b (iC3b) virker anafylatoksisk?
1. Fremmer fagocytoptagelse af partikler og opløselige immunkomplekser gennem opsinosering
2. Medvirker i erytrocyt medieret fjernelse af opløselige immunkomplekser fra blodbanen
Beskriv hvordan C3d (iC3b) virker anafylatoksisk?
Hjælper med at inducere antigenmedieret B celle proliferation
Beskriv hvordan C5bC69 virker anafylatoksisk?
1. Lyserer gram negative bakterier, inficerede værtsceller og visse virus
2. Stimulerer diverse celler til cytokin og leukotrinproduktion
Beskriv hvordan C1q og MBL virker anafylatoksisk?
Fremmer fagocytose
Beskriv opbygning af defensiner
De består af 30-40 aminosyrer og inddeles i a og b defensiner.
De indeholder både hydrofile og hydrofobe områder, og dermed kan de gennemtrænge mikrobielle membraner
Hvad er defensiners hovedfunktion?
At bekæmpe mikroorganismer og inducere død af bakterie, svampe eller virus.
De sætter sig i cellemembranen som porelignende strukturer.
Beskriv alfa defensiner
De indeholder en alfa helix.
Dannes af neutrofile granulocytter og panethceller i tarmen.
Beskriv beta defensiner
De har et betafoldet område.
De dannes hovedsageligt af epithelceller
Beskriv pentraksiner
Det er proteiner der binder Ca2+ afhængigt til deres ligander.
CRP syntentiseres i leveren og er med til og aktivere den klassiske aktiveringsvej
SAP transporterer kolesterol til leveren og det inducerer enzymer der nedbryder bindevæv og rekruttere immunceller til det betændte område.

Hvilke celler benytter det innate immunsystem sig af?
De myeloide celler
- Monocytter og makrofager
-Neutrofile
-Eosinofile
-Basofile
Og NK celler
Hvad er NK cellens funktion?
At dræbe tumorceller og virusinficerede celler uden at have mødt dem før
Hvad fører til NK cellens drab?
1. Binding af IgA, IgG eller C3 fragmenter fører til NK drab
2. Nedsat ekspression af MHC I
Hvilke celler hører under de myeloide stamceller?
Monocytter
Makrofager
Granulocytter
Dendritiske celler
Hvordan aktiveres de myeloide celletyper?
De genkender molekylære mønstre på overfladen af mikroberne
Beskriv monocytter
De er nyrer formet.
De har et veludviklet golgi og mange lysosomer der indeholder enzymer som kan slå andre celler ihjel.
Deres funktion er at fagocytere og nedbryde invaderende mikroorganismer.
Derudover skal de også danne cytokiner og tilkalde og aktivere andre celler.
Hvor bevæger de fleste moncytter sig hen, og hvad omdannes de til?
De bevæger sig ud i vævet hvor de omdannes til makrofager.
De kan dog også omdannes til dendritiske celler.

Beskriv makrofagerne
De er store celler og kan have cytoplasmatiske udløbere.
De har et veludviklet ER, golgi og indeholder mange lysosomer.
De skal angribe mikrober og er også vigtige APC'er.
De danner forskellige stoffer der anvendes i opbygning af skadet væv.
De har lang levetid og dør ikke før de har udført fagocytose.

Hvilke stoffer danner makrofagerne der er vigtige for genopbygningen af væv?
Elastase
Kollagenase
Fibrinogen
Makromolekyler
Hvilke former for granulocytter findes der?
1. Neutrofile
2. Eosinofile
3. Basofile
4. Mastceller
Beskriv de neutrofile granulocytter
De udgør størstedelen af granulocytterne.
De indeholder polymorfe kerner
De modnes i knoglemarven, kommer ud i blodet og vandre til vævet hvor de kun overlever et par dage.
De er første forsvar mod mikroorganismer, og deres hovedfunktion er fagocytose.
Hvad kan neutrofile granulocytter efter deres død undergå?
NETose
- De omdannes til et net der kan omgive bakterier og slå dem ihjel

Beskriv eosinofile granulocytter
De udgør omkring 3% af leukocytterne i blodet.
Antallet stiger kraftigt under orme og parasit infektioner.
De har en to lappet kerne der indeholder en masse granula med enzymer i.
De udskiller toksiske stoffer gennem exocytose og dræber dermed orme og parasitter.
De er ikke fagocytter, da deres virkningsmekanisme er degranulering.
De binder til overfladen af mikroorganismer der er for store til at blive fagocyteret og frigiver indholdet i deres granula.

Beskriv de basofile granulocytter
Udgør omkring 1%
Deres funktion er at inducere inflammation, samt aktivere eller inhibere de andre leukocytter.
Deres primære funktion er degranulering og dermed hører de ikke under fagocytterne.
De indeholder en lang række sekretorisk granula og spiller en stor rille i antiparasitisk immunitet og allergiske reaktioner.
De binder til overfladen af organismer der er for store til at blive fagocyteret og frigiver indholdet i deres granula.
Beskriv mastcellerne
De findes kun i vævet.
De indeholder granula, og dette frigives hvis der er IgE til stede.
Indeholder
- Histamin
- Serotonin
-Kemotaktiake faktorer
-Leukotriner
Beskriv de dendritiske celler
De har lange udløbere, og har en lang række mønstergenkendende receptorer.
De fungerer som APC'er.
Beskriv type I fagocytose
1. Mikoorganismen bliver genkendt af fagocyttens Fcy receptor
2. Når mikroben binder til receptoren, bygger aktin sig op til en nålelignende struktur der kan skubbe cellemembranen ud ad
3. Der dannes filipodier og lamel podier der kommer i kontakt med mikroben.
4. Cellen fungerer nu som en lynlås der lukker sig omkring mikroben.
5. Fagocytten indtager bakterien og danner et fagosom som kan nedbrydes.

Beskriv type II fagocytose
1. Udløses når CR3 og integriner detekterer stoffer der skal nedbrydes eller fjernes
2. Fagocytten indeholder stressfibre der består af aktin, som kan trække partiklen ind i cellemembranen.
3. Stress fibrene trækker partiklen ind i cellen hvor den kan nedbrydes

Hvad omdannes mikroorganismen til, når den bliver fagocyteret?
Når fagocytten har omdannet mikroorganismen, dannes der et fagosom.
Fagosomet fusionerer med et cytoplasmatisk lysosom, og man har nu et fagolysosom.
Beskriv pinocytose
1. Der afsnøres større eller mindre mængder af den omkringliggende væske.
2. Der dannes endosomer
3. Endosomerne smelter sammen med lysosomerne som indeholder fagocyttens nedbrydende eller dræbende faktor.
Beskriv NET
Neutrofile granulocytter indgår i en process hvor cellens kromatin udfoldes til et net.
I nettet sidder der nogle antibakterielle peptider og enzymer.
Nettet indfanger bakterier og slår dem herefter ihjel.

Beskriv NK cellens drabsmekanisme
NK cellen danner en synapse til målcellen.
Der er flere måder hvor på NK cellen kan dræbe de virusinficerede celler.
1. NK cellens granula indeholder perforiner der danner porer i målcellens membran. Hermed får granzymer og serin proteaser adgang til målcennels kerne og slår cellen ihjel.
2. Fas/Fasl interaktion:
NK cellen inducerer apoptose ved secernering af TNF-a. Dette gør at cellen går i apoptose og danner inflammation så virus ikke spredes

Hvad er inflammation?
Det er den lokale reaktion der opstår når der kommer en infektion
Nævn kort trinnene i inflammation:
A. Skade
B. Komplement aktiveres
C. Mastceller degranulere
D. Makrofager aktiveres
E. Endothelceller udtrykker IL-8
F. Neutrofile granulocut infiltration
G. Monocyt infiltration
H. Koagulation
Nævn kardinal tegnene
Rubor
Dolor
Calor
Tumor
Functio laesa
Beskriv inflammationens begyndelse
1. Det innate immunsystem genkender bakterierne gennem PAMPS
2. Dette aktiverer komplementsystemet
3. Der frigives en lang række mediatorer som igangsætter inflammationsprocessen
Hvilke mediatorer frigives som igangsætter inflammationsprocessen?
Bradykinin:
-Kar dilaterende
-Inducerer smerte
Anafylatoksiner frigives
- Inducerer kontraktion af glat muskulatur
-Øger karpermeabilitet
-Er kemotaktisk
-Inducerer degranulering
Prostaglandiner
- Kardilaterende
-Øger kar permeabilitet
TNF-a
- Påvirker endothelcellerne
Beskriv marginalisering
Når endothelcellerne udviser adhæsionsproteiner og IL-8 på overfladen, så kan fagocytterne hæfte sig fast.
Cellerne kan nu bevæge sig gennem endothelet gennem marginalisering

Beskriv diapedese
Cytokinerne TNF-A, IL-1b og IL-8 spiller en stor rolle i leukocytternes migration til det inficerede væv.
TNF-a og IL-1b nedsætter leukocytternes flow således at leukocytterne ruller langs karvæggen i stedet for og rulle hurtig forbi.
IL-8 ændre overfladen af endothelceller så cellerne stopper helt op. Herfra kan leukocytterne invadere endothelcellerne.
Cellerne presser sig gennem endothelet gennem diapedese.
